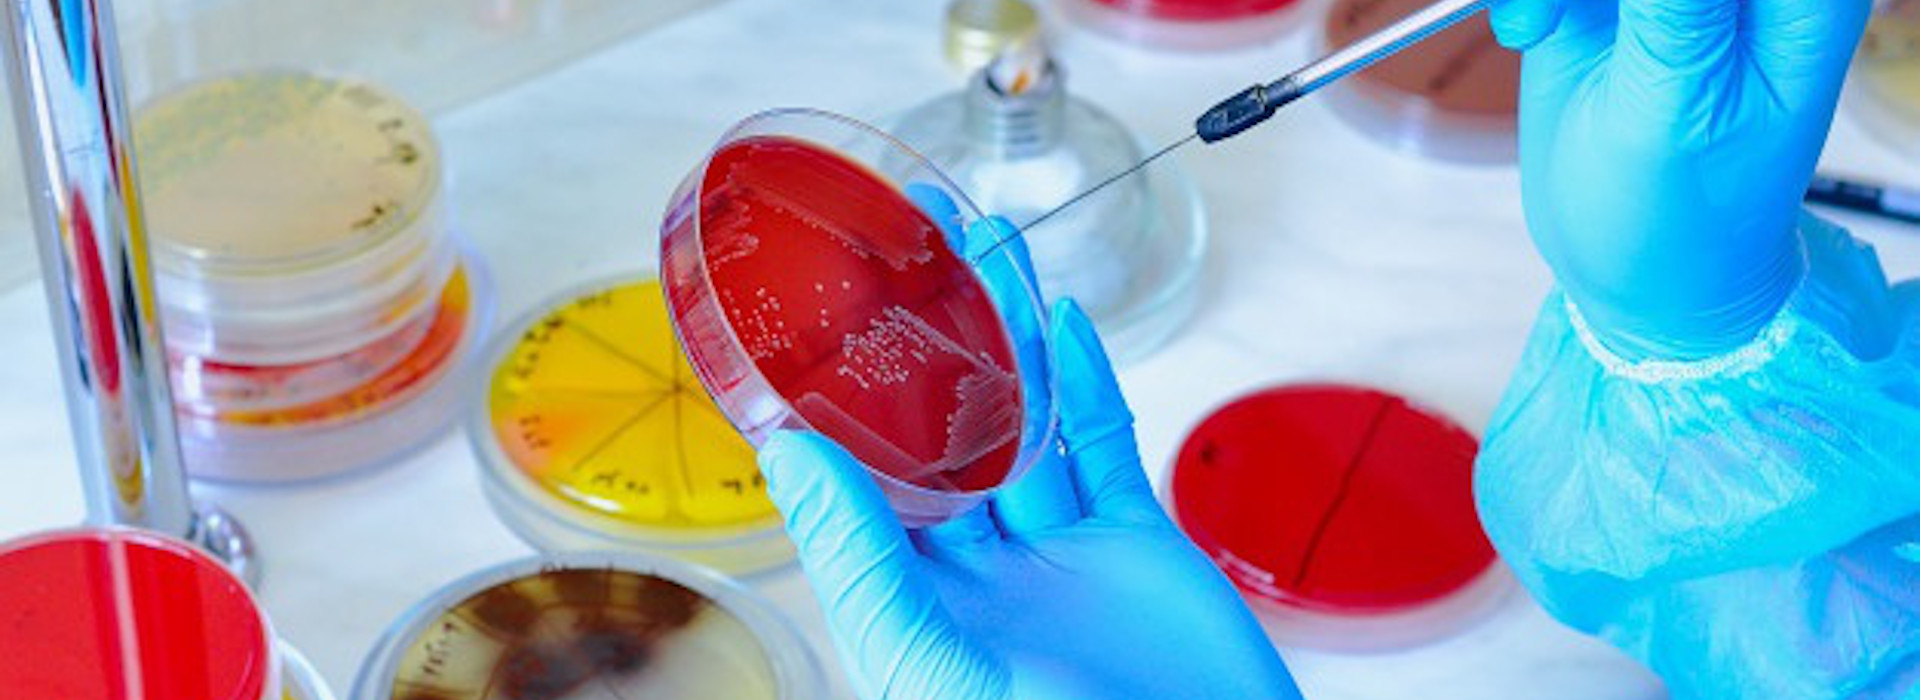

Antimicrobico-resistenza: Rapporto congiunto Efsa-Ecdc
L'antimicrobico-resistenza rappresenta una delle sfide sanitarie globali più urgenti del nostro tempo. Un recente rapporto congiunto dell'Autorità europea per la sicurezza alimentare (Efsa) e del Centro europeo per la prevenzione e il controllo delle malattie (Ecdc) fornisce una panoramica dettagliata di questa minaccia crescente.
In questo articolo, esploriamo i punti salienti del rapporto Efsa-Ecdc, le implicazioni per la salute pubblica e le misure necessarie per combattere l'antimicrobico-resistenza.
Punti salienti del rapporto congiunto Efsa-Ecdc
Il rapporto Efsa-Ecdc evidenzia come l'antimicrobico-resistenza stia continuando a diffondersi a livello globale, influenzando non solo la salute umana ma anche quella animale e ambientale. Tra i principali punti emersi, troviamo:
- Incremento delle Resistenze Multiple: È stato osservato un aumento delle resistenze multiple, dove batteri patogeni sono resistenti a più classi di antimicrobici, rendendo le infezioni più difficili da trattare.
- Differenze Geografiche: La diffusione della resistenza varia significativamente tra i diversi Paesi europei, con alcune regioni che mostrano tassi di resistenza molto più elevati rispetto ad altre.
- Trasmissione tra Specie: La resistenza antimicrobica non è limitata agli esseri umani; anche gli animali da allevamento e gli alimenti possono essere vettori di batteri resistenti, dimostrando la necessità di un approccio One Health.
Implicazioni per la salute pubblica
L'antimicrobico-resistenza pone seri rischi per la salute pubblica. Le infezioni causate da batteri resistenti possono portare a malattie più gravi, degenze ospedaliere prolungate e un aumento dei tassi di mortalità. Inoltre, l'uso inefficace degli antibiotici può portare a costi sanitari più elevati e a un maggiore carico sui sistemi sanitari già sotto pressione.
Misure necessarie per combattere l'antimicrobico-resistenza
Il rapporto Efsa-Ecdc sottolinea l'urgenza di implementare misure efficaci per contrastare l'antimicrobico-resistenza. Ecco alcune delle azioni raccomandate:
- Promozione dell'Uso Responsabile degli Antimicrobici: È fondamentale educare sia i professionisti della salute che i cittadini sull'uso corretto degli antibiotici, evitando l'uso eccessivo e inappropriato.
- Monitoraggio e Sorveglianza: Rafforzare i sistemi di monitoraggio e sorveglianza per rilevare precocemente i casi di resistenza e adottare misure di controllo adeguate.
- Ricerca e Sviluppo: Incentivare la ricerca e lo sviluppo di nuovi antimicrobici, trattamenti alternativi e vaccini per ridurre la dipendenza dagli antibiotici esistenti.
- Approccio One Health: Adottare un approccio integrato che consideri la salute umana, animale e ambientale, promuovendo la cooperazione tra diversi settori e discipline.
- Politiche e Regolamentazioni Strutturate: Implementare politiche e regolamentazioni a livello nazionale e internazionale per controllare l'uso degli antimicrobici e prevenire la diffusione della resistenza.
L'antimicrobico-resistenza è una minaccia che richiede un'azione immediata e coordinata. Il rapporto congiunto Efsa-Ecdc fornisce un quadro chiaro della situazione attuale e delle misure necessarie per affrontare questa sfida. Implementando le raccomandazioni fornite, possiamo proteggere la salute pubblica e garantire un futuro più sicuro e sostenibile.